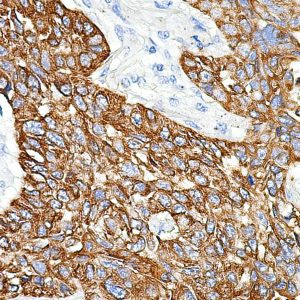
AM133
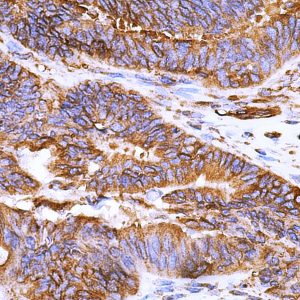
AM122
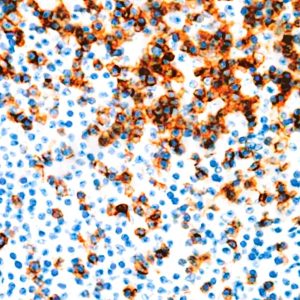
AM113

Both
Showing 661–680 of 703 resultsSorted by latest
-

Anti-CD74 (B cell)
Price range: $250.00 through $935.00 Select options This product has multiple variants. The options may be chosen on the product page -

Anti-Cytokeratin 14
Price range: $250.00 through $1,160.00 Select options This product has multiple variants. The options may be chosen on the product page -

Anti-Cytokeratin 18
Price range: $250.00 through $1,045.00 Select options This product has multiple variants. The options may be chosen on the product page -

Anti-Cytokeratin 8
Price range: $250.00 through $935.00 Select options This product has multiple variants. The options may be chosen on the product page -

Anti-Breast Cancer Antigen (BCA) 225
Price range: $250.00 through $919.00 Select options This product has multiple variants. The options may be chosen on the product page -
Anti-Cytokeratin HMW (Basic)
Price range: $250.00 through $1,105.00 Select options This product has multiple variants. The options may be chosen on the product page -

Anti-Cytokeratin 13
Price range: $229.00 through $732.00 Select options This product has multiple variants. The options may be chosen on the product page -

Anti-Cytokeratin 8 &18
Price range: $260.00 through $1,360.00 Select options This product has multiple variants. The options may be chosen on the product page -

Anti-Actin; Smooth Muscle
Price range: $260.00 through $1,465.00 Select options This product has multiple variants. The options may be chosen on the product page -

Anti-Chromogranin A
Price range: $350.00 through $1,305.00 Select options This product has multiple variants. The options may be chosen on the product page -
Anti-Beta-Tubulin
Price range: $300.00 through $905.00 Select options This product has multiple variants. The options may be chosen on the product page -

Anti-Alpha-Tubulin
Price range: $300.00 through $905.00 Select options This product has multiple variants. The options may be chosen on the product page -
Anti-CD45RO (T Cell)
Price range: $260.00 through $1,305.00 Select options This product has multiple variants. The options may be chosen on the product page -

Anti-CD45 (Leukocyte common Antigen, LCA)
Price range: $250.00 through $1,079.00 Select options This product has multiple variants. The options may be chosen on the product page -

Anti-Myosin, Skeletal Muscle
Price range: $350.00 through $935.00 Select options This product has multiple variants. The options may be chosen on the product page -

Anti-Alpha-Actinin
Price range: $335.00 through $965.00 Select options This product has multiple variants. The options may be chosen on the product page -

Anti-Actin; Muscle-Specific
Price range: $416.00 through $1,195.00 Select options This product has multiple variants. The options may be chosen on the product page -

Anti-Melanoma-Associated Antigen
Price range: $260.00 through $1,395.00 Select options This product has multiple variants. The options may be chosen on the product page -

Anti-Cytokeratin, Low MW
Price range: $260.00 through $1,119.00 Select options This product has multiple variants. The options may be chosen on the product page -

Anti-Vimentin
Price range: $260.00 through $1,125.00 Select options This product has multiple variants. The options may be chosen on the product page

